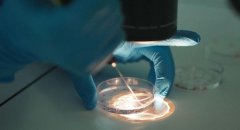
泰国试管多少钱？一文给你讲清楚！

泰国试管婴儿价格

-
 泰国“私人订制”试管之旅:价格揭秘与“过来人”的经验大放送!
泰国“私人订制”试管之旅:价格揭秘与“过来人”的经验大放送!随着技术的不断进步,试管技术也在发展,现在有越来越多的夫妻选择到国外去做试管疗程,泰国作为试管疗程最受欢迎的国家之一,吸引了很多夫妻到泰国进行试管疗程。
作者:wednesday 56 发布时间:2026-05-11 -
 试管宝贝计划大揭秘!去泰国造人,你的预算够了吗?
试管宝贝计划大揭秘!去泰国造人,你的预算够了吗?近年来,试管技术被越来越多的人采用,但是价格也是有讲究的,有时甚至会影响到宝宝的发展。为了让大家在避免浪费时间和金钱的基础上,更加清楚的了解试管技术的收费情况,
作者:wednesday 143 发布时间:2026-05-11 -
 泰国试管双胞胎:一次治疗需要多少花费?
泰国试管双胞胎:一次治疗需要多少花费?许多家庭怀揣着美好的愿景,梦想着通过一次生育两个孩子来减轻育儿负担,并期待孩子们能在成长道路上彼此陪伴、相互扶持。为此,一些人选择前往海外寻求试管治疗,以实现双胞胎的
作者:木易 181 发布时间:2026-05-11 -
 泰国试管的费用贵吗?看看具体需要多少?
泰国试管的费用贵吗?看看具体需要多少?相信大家都知道,泰国的试管技术是数一数二的,因为泰国拥有非常先进的医疗设备,且医师资源庞大,所以做试管的成功率也比较高。但要知道的是,目前在泰国做试管的费用也比较贵的,
作者:兰兰 195 发布时间:2026-05-11 -
 2024泰国三代试管费用价格表大公开,想生'男'孩的夫妻看过来!
2024泰国三代试管费用价格表大公开,想生'男'孩的夫妻看过来!2024泰国三代试管费用概览:梦想生男孩的夫妻必读!尽管海外试管费用普遍偏高,且普遍采用先进的三代试管技术,增加了成本,但泰国作为热门选择,其试管费用实则相对亲民,大约在9-12万
作者:木易 124 发布时间:2026-05-11 -
 在齐齐哈尔第一医院做试管大概要花多少钱?费用明细项目如下
在齐齐哈尔第一医院做试管大概要花多少钱?费用明细项目如下齐齐哈尔市第一医院试管费用全面解读,从检查要移植每一笔都有迹可循,试管作为一种助孕手段深受广大不孕不育患者青睐,但试管费用是很多患者比较在意的一个问题,而在齐齐哈尔
作者:木易 124 发布时间:2026-05-11 -
泰国试管多少钱?一文给你讲清楚!
泰国试管多少钱?一文给你讲清楚!试管技术已经成为不孕不育患者实现生子梦的最好方法之一,然而做试管是有一定条件的,由于大多数家庭都不是非常富裕,导致去做试管的患者都是发现试管的费用高不高
作者:木易 75 发布时间:2026-05-11 -
 泰国做试管需要多少费用?一起来了解一下!
泰国做试管需要多少费用?一起来了解一下!泰国的试管治疗费用大约在30万-40万泰铢之间,相当于6000-8000美元。这价格相对其他国家较为便宜,吸引了越来越多人选择在泰国接受这项治疗。对比其他国家,泰国的试管治疗费用更
作者:多米 52 发布时间:2026-05-11 -
 泰国杰特宁医院供精试管全攻略:费用清单大揭秘!
泰国杰特宁医院供精试管全攻略:费用清单大揭秘!泰国杰特宁医院供精试管多少钱,这份供精费用清单请查收!众所周知,泰国的试管技术是很不错的,不仅成功率高,其费用也比美国要低,并且政策也相对宽松,因此,国内很多有试管需求的
作者:wednesday 164 发布时间:2026-05-11 -
 2024泰国做第三代试管费用是多少?泰国试管价格为什么低
2024泰国做第三代试管费用是多少?泰国试管价格为什么低泰国进行第三代试管的费用相对较低,大约在15万-30万泰铢(约合人民币3.4万-6.8万)之间。这得益于泰国医疗成本低、设施完备、专业团队经验丰富以及政府对医疗旅游行业的支持。患者在选
作者:月月 146 发布时间:2026-05-11 -
 泰国ibaby爱宝贝生殖中心试管收费表
泰国ibaby爱宝贝生殖中心试管收费表IBaby爱宝贝试管生殖基因中心(泰国) ibaby爱宝贝生殖基因中心价目单 项目 明细 泰铢 四选一 促排 取卵OPU 卵泡浆内单精子显微注射ICSI 鲜胚移植ET 套餐① _含3,000U促排卵药剂量 _传染病/激素检
作者:admin 62 发布时间:2026-05-11 -
 泰国BNH医院试管多少钱收费表
泰国BNH医院试管多少钱收费表BNH试管收费表 第一阶段:进行试管治疗前检查 泰铢Baht 1.一般性验血测试: 7830 血常规,血型,正负血型,甲状腺功能测试,血红蛋白,艾滋病病毒,每对血清测试,乙肝肝炎抗原,
作者:admin 182 发布时间:2026-05-11
- 上一页
- 34
- /34
- 末页
